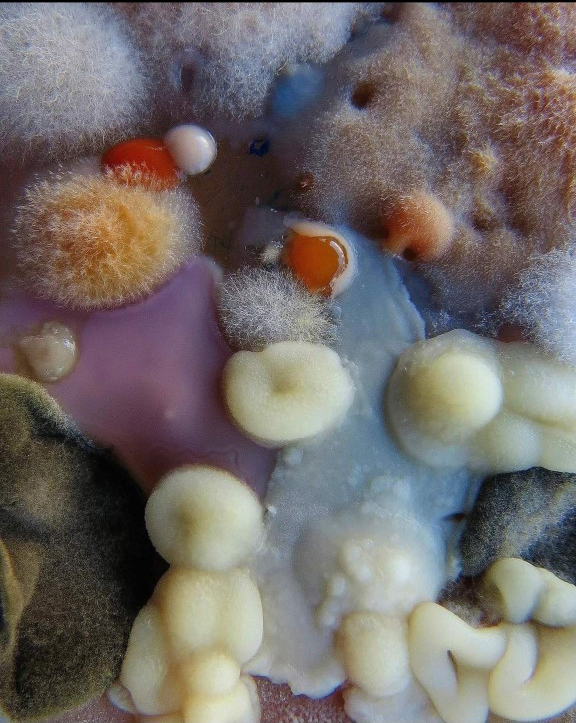
/forum/uploads/images/1659/thumbnail_screenshot_2022-05-23-14-16-13-090_co.jpg
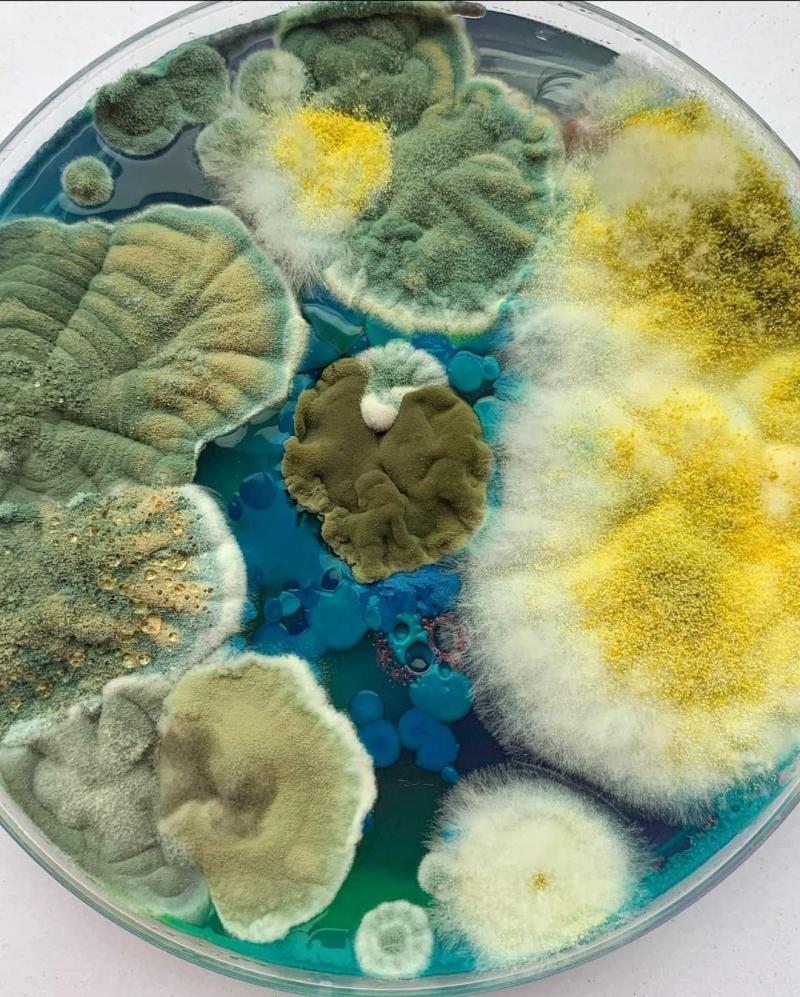
/forum/uploads/images/1659/screenshot_2022-05-23-14-16-28-603_comfacebookk.jpg
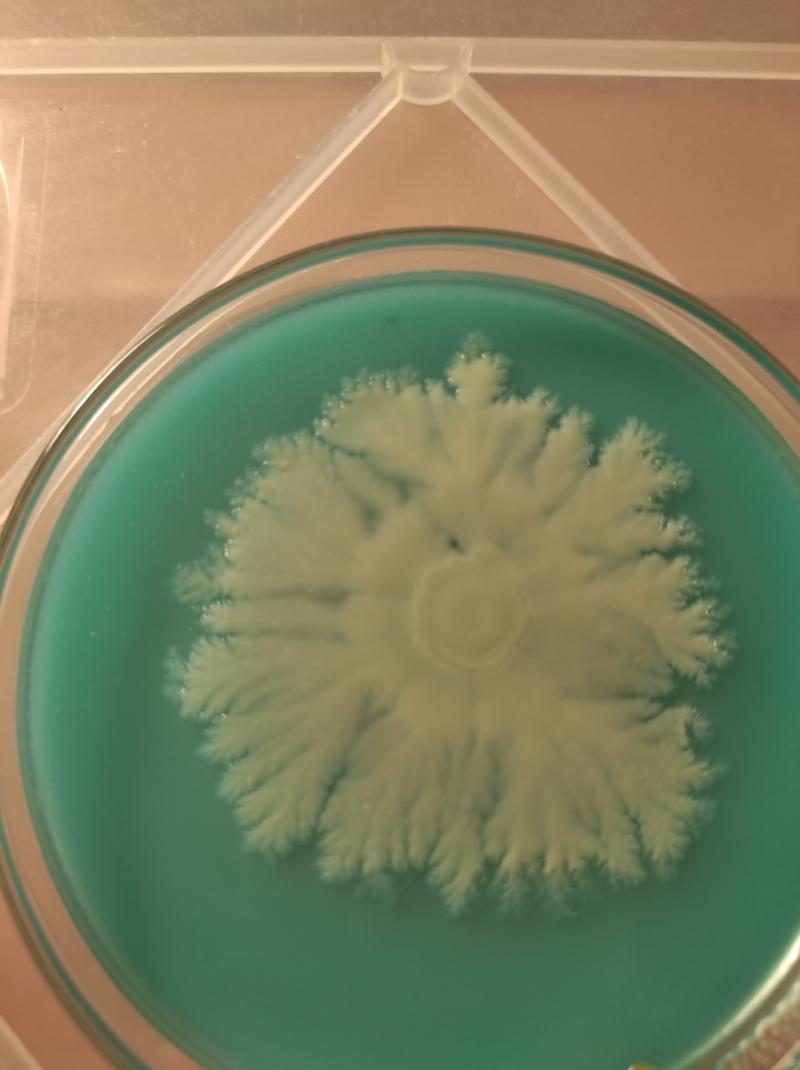
/forum/uploads/images/1659/thumbnail_img_20211006_230629.jpg

[ Culture ]
Totoriel, travailler avec des milieux gélosés

- MikeO'ryize

Psycho junior
- 03 août 2022 à 01:26

Les géloses sont utilisées en mycologie pour faire germer des spores, multiplier du mycélium, ou pour cloner des champignons à partir de tissus, tout en s'assurant de l'absence de contamination dans le matériel génétique utilisé. Les boites de Petri sont généralement utilisées comme récipients pour ces milieux. Le principal ingrédient commun à ces milieux portant le noms de gélose est l'agar-agar qui est un gélifiant naturel issu de plusieurs algues rouges. Leur composition peut varier, mais elles contiennent toutes pour la culture des champignons du sucre (plus d'autres ingrédients qui varient en fonction des recettes) et de l'eau. Elle permettent de cultiver en 2D le mycélium sur une surface semi-solide ce qui leur confère bien des avantages lors de nombreuses étapes de la culture.
Elles sont (presque) indispensables à un niveau avancé de mycologie, et permettent de sauver beaucoup de temps en limitant grandement les possibilités d'inviter des contaminations dans les premières étapes du processus de la culture. (ex: contrôle de culture liquide ou de solution de spores). Si les bactéries et les champignons, que l'on appelle (de manière réductrice) contaminations sont présents partout atour de nous, ils restent néanmoins invisibles pour nos yeux. Les géloses permettent de les révéler de manière macroscopique :
C'est des photos d'une artiste (dont j'ai oublié le nom) qui s'occupe à faire de l'art avec les choses qui nous sont habituellement invisibles et qui nous sont rendues à la vue par ses mains et grâce aux géloses. En clair, c'est exactement de toutes ces choses que nous autres myciculteurs, ne voulons par sur nos boîtes
Même si parfois des petits "accidents" donnent lieu à de drôles de rencontres :
C'est surement un organisme du groupe des myxomycètes rencontré dans l'une de mes boîtes que je ne sais pas identifier, si l'un de vous a une idée (sait-on jamais  )
)
Les géloses peuvent être également utilisées pour obtenir un mycélium rizomorphique par des isolations successives en coupant un morceau de gélose où le mycélium qui s'y développe semble le plus ramifié en opposition au mycélium cotonneux. Elles peuvent être aussi utilisées comme sauvegarde dans le temps d'un matériel génétique en étant placées au frigo à condition de les entourer de parafilm pour éviter qu'elles ne se dessèchent. Elle peuvent également servir de point de départ pour la colonisation du grain à la place de la culture liquide ou de la solution de spores.
Quand le mycélium est organisé de manière rizomorphique ça peut donner de jolies choses de la sorte :
crédit photo: basidium_equilibrium
Et le but de la manoeuvre n'est pas simplement esthétique, en faisant des isolations successives l'on finit par isoler un seul "individu", un seul génotype qui de ce fait poussera plus vite qu'en présence d'autres individus compétiteurs. On gagne donc en vitesse de colonisation du grain, du substrat, ce qui peut éviter aussi à cause d'une colonisation trop lente des problèmes de contamination.
Le but de ce topic est de donner une recette simple et fonctionnelle (sans doute pas la meilleure) mais qui a néanmoins le mérite de pouvoir être réalisée avec des ingrédients que l'on peut se procurer sans difficulté dans les grandes surfaces. La méthode exposée ici a aussi l'avantage de rendre le travail sur agar moins impressionnant et donc plus accessible
Pour cette méthode vous aurez besoin des ingrédients suivants:
- Flocons de pomme de terre (type purée mousseline déshydratée)
- Agar-agar (qu'on trouve au rayon pâtisserie des supermarchés)
- Eau du robinet
- Une source de sucre (tout type de sirop contenant du glocose-fructose)
- Colorant alimentaire (facultatif)
Le matériel suivant sera nécessaire:
- Balance précise au gramme
- Récipient pour contenir les différents ingrédients
- Une ou plusieurs bouteilles en verre
- Autocuiseur
- Pots de sauce plastique/petits récipients en verre avec couvercle/boîtes de Petri
- Coton
- Papier aluminium
Les quantité ci-après sont utilisées pour concocter aux environs de 200ml de milieu gélosé, (ce qui correspondait à environ 15 boites de ketchup une fois coulées):
- 6g de flocons de purées
- 4g d'agar-agar
- 2 gramme de sirop (ici du sirop de grenadine)
- 200 ml H20
Étape 1:
Peser successivement les ingrédients dans un récipient (un pot en verre de plus de 200ml fait très bien l'affaire)

Étape 2:
Ajouter 200ml d'eau préalablement portée à ébullition 
Incorporer 2 ou 3 goutes de colorant 
L'ajout de colorant alimentaire n'est pas obligatoire, mais il permet de mieux distinguer la présence de colonies bactériennes ou fongiques dont la couleur a tendance à se confondre avec celle de la gélose.
Agiter l'ensemble de la mixture afin d'obtenir une solution (visqueuse) à peu près homogène
Étape 3:
Verser la solution dans le contenant en forme de bouteille de votre choix (j'utilise une bouteille de sauce à nems et des bouteilles de bière généralement). La bouteille ne doit surtout pas être remplie à plus de la moitié voir des 2/3 pour éviter tout débordement pendant la stérilisation. Il est préférable d'avoir un entonnoir pour réaliser cette étape, mais n'en ayant pas, j'utilise le dessus de ma cafetière à l'italienne 
La forme de bouteille est également utile pour la suite afin de verser facilement l'agar dans les pots.
Étape 4:
Lors de cette étape, il s'agit de confectionner un bouchon pour les bouteille avant la cuisson. Il faut en effet un bouchon qui laisse la vapeur entrer dans les bouteilles pour que la pression s'équilibre et qu'elles n'éclatent pas. Pour ce faire, il faut placer un bouchon de coton que l'on pourra sortir après cuisson dans le goulot, puis le recouvrir d'une petite feuille d'aluminium


Étape 5:
Il faut maintenant passer à l'étape de la stérilisation. Il faut donc préparer son autocuiseur de la façon dont vous avez l'habitude de faire en ajoutant la bonne quantité d'eau, et placer la ou les bouteilles à l'intérieur (Il est préférable d'ajouter de l'eau chaude dans l'autocuiseur, afin de ne pas éclater le contenant par choc thermique. Il faut veiller aussi à placer quelque chose dans le fond de l'autocuiseur pour que la bouteille ne soit pas en contact direct avec le fond, j'utilise pour ça un vieux teeshirt) Elles peuvent être légèrement inclinées pour rentrer, mais pas couchées. Commencer à cuire à feu doux puis augmenter progressivement au bout de 10minutes, et compter 30 minutes de cuisson à partir du moment où de la vapeur commence à sortir.

Étape 6:
[justify]Une fois les 30min écoulées, c'est le moment de sortir la bête! Il ne faut surtout pas attendre la nuit comme on peut avoir l'habitude de faire avec le grain ou les PF-Tek, puisque la gélose se solidifie en refroidissant, quand sa température redescend autour de 40°C. Dès lors une petite course contre la montre commence puisqu'il va s'agir de couler toutes vos géloses avant que le tout ne prenne en masse dans votre bouteille, sous pêne de devoir recommencer la cuisson.
Il faut alors préparer son plan de travail, ainsi que sa SAB (Still Air Box) désinfecter le tout à l'alcool, ainsi que ses mains et avoir les pots de ketchup à disposition. Il n'est pas nécessaire ni de nettoyer, ni de stériliser ces pots qui sont plutôt stériles par expérience en l'état. Il faut placer tous les pots que vous comptez couler lors de la manipulation à l'intérieur de la SAB
Pour savoir quand c'est le bon moment pour couler les géloses, rien n'est plus simple. À partir du moment où votre main supporte la chaleur du récipient sans se bruler, c'est que c'est le moment d'y aller.
C'est à ce moment qu'il ne faut pas trainer, et qu'il faut être aussi précis. J'ouvre à partir de là 3 pots à l'avent de ma SAB et je les coule successivement. Je mets entre 0,5 et 0,7 cm de gélose dans chaque pot, c'est la bonne quantité. Et je place ensuite délicatement pour ne pas avoir de gélose sur les bords de mes pots, ces derniers au fond de la SAB pour couler les suivant. Répéter l'opération jusqu'au ne plus avoir de gélose et laisser le tout sécher bien à plat (laisser au moins 1h sans ne plus toucher à rien
Bon comme vous pouvez le constater, c'est ni évident de ne pas en mettre sur les bords parce que les pots ne sont faciles à fermer puisqu'ils se dilatent avec la chaleur, et c'est ni évident de respecter les 0,5 à 0,7 cm. C'est les seuls inconvénients de ces petits pots. Je sais maintenant passé à des boîtes de Petri en verre qui possèdent l'avantage d'être beaucoup moins délicates à gérer à cette étapes, mais elles ont aussi leurs lots d'inconvénients.
Maintenant que vous avez toute votre armada de gélose à dispositon, à vous les expériences génétiques de petits mycologistes en herbe !
Pour illustrer les techniques de transfert:
Je suis juste pas très sur que désinfecter le champignon à l'alcool soit une bonne idée si vous voulez le consommer par la suite. Pour éviter cette étape, il suffit juste de déchirer en deux le champignon par le pied avec vos doigts et des prélever un morceau de tissu à son coeur qui n'a pas été en contact avec l'extérieur

Un petit exemple du beau mycélium que l'on peut obtenir par la présente technique après quelques isolations
Puis des fois aussi il arrive des choses formidables quand le mycélium est bien vigoureux (et qu'on oublie un peu les boîtes aussi)
Voilà c'est tout pour moi, maintenant ne tient qu'à vous de vous lancer à scalpel perdu dans ce délicieux monde de gelé bien plus appétant que les immondes Jelly de nos voisins outre-Manche 
Dernière modification par MikeO'ryize (03 août 2022 à 11:59)
La fin est en germe dans le début
Hors ligne
- Moth

Nouveau membre - 03 août 2022 à 09:42
On peut quand on en a utiliser l'eau de trempage / cuisson du grain avec uniquement de l'agar.
Je voudrais savoir où tu as acheté tes pots à sauce et la marque si possible.
:)
Hors ligne

- MikeO'ryize

Psycho junior
- 03 août 2022 à 11:40
Je t'avoue que j'ai jamais essayé avec l'eau de cuisson parce que c'est rare que je sois synchronisé entre les moments où je fais le grain et celui où je fais les géloses, mais je pense que ça doit bien fonctionner également
Sans donner le nom exacte j'étais passé par un truc qui s'appelle presque "la boutique de ce qui se jette", et j'avais à l'époque acheté pour 20€ avec la livraison 150 pots. Mais j'ai pas retrouvé les références de ce que j'avais acheté, c'est possible qu'avec les lois écologiques sur les trucs plastique à usage unique ils aient moins ou plus le droit de vendre des choses de ce genre. Pareil pour le géant de la distribution américain ça a pas l'air d'être encore possible d'acheter ça je viens de regarder. Mais en creusant un peu plus c'est possible d'en trouver. En passant par la version américaine de ce même géant, on en trouve, juste que les frais de livraison sont un peu plus reuch. Et pour préciser à l'époque j'avais pris des contenants de 60 et 90ml en PET et PP qui font très bien l'affaire. Je pense aussi que tu peux demander à ton kebabier préférer de t'en vendre un peu ou à minima de lui demander la ref de son fournisseur. Puis j'ai vu un truc dont il faut à mon avis se méfier, il existe surement à cause de cette même loi des pots en amidon, qui ne doivent ni résister à la chaleur, ni même à l'appétit des champignons
Dernière modification par MikeO'ryize (03 août 2022 à 12:05)
La fin est en germe dans le début
Hors ligne
- Moth

Nouveau membre - 04 août 2022 à 09:46
Quant à l'eau du grain tu peux tout simplement la mettre dans une bouteille au frigo et ça se garde des semaines ou alors faire des glaçons avec afin d'avoir les dosages déjà fait, certains font même les glaçons avec l'agar dedans comme ça plus qu'à les mettre dans la bouteille puis au PC pour aller encore plus vite ...
Hors ligne

- MikeO'ryize

Psycho junior
- 10 août 2022 à 18:56
Je tenterai peut-être un jour l'expérience des géloses avec l'eau de cuisson, mais c'est vrai qu'une fois qu'on a trouvé ce qui marche pour nous on a plus trop tendance à vouloir expérimenter de nouvel agencement
La fin est en germe dans le début
Hors ligne
- anonyme 87

Nouveau Psycho
- 11 août 2022 à 08:57

Hors ligne

- MikeO'ryize

Psycho junior
- 11 août 2022 à 12:20
Il y a la célèbre JOC PAN TEK sur le forum dont tu parles (mais ça tu dois déjà être au courant), mais il y a aussi GordoTEK qui a sorti il y a peu une méthode super simple et accessible à mon avis sur le sujet. C'est la méthode que je vais suivre pour ma première tentative et tu peux la trouver ici:
https://odysee.com/@GordoTEK:1/GTEK-Pan … 3500kbps:1
Je pense que si ça fonctionne pour moi, je vais en faire une traduction en français ici par la suite pour la rendre plus accessible

La fin est en germe dans le début
Hors ligne
» [ Culture ] Totoriel, travailler avec des milieux gélosés
Affichage Bureau - A propos de Psychoactif - Politique de confidentialité - CGU - Contact -

Soutenez PsychoACTIF
Soutenez PsychoACTIF